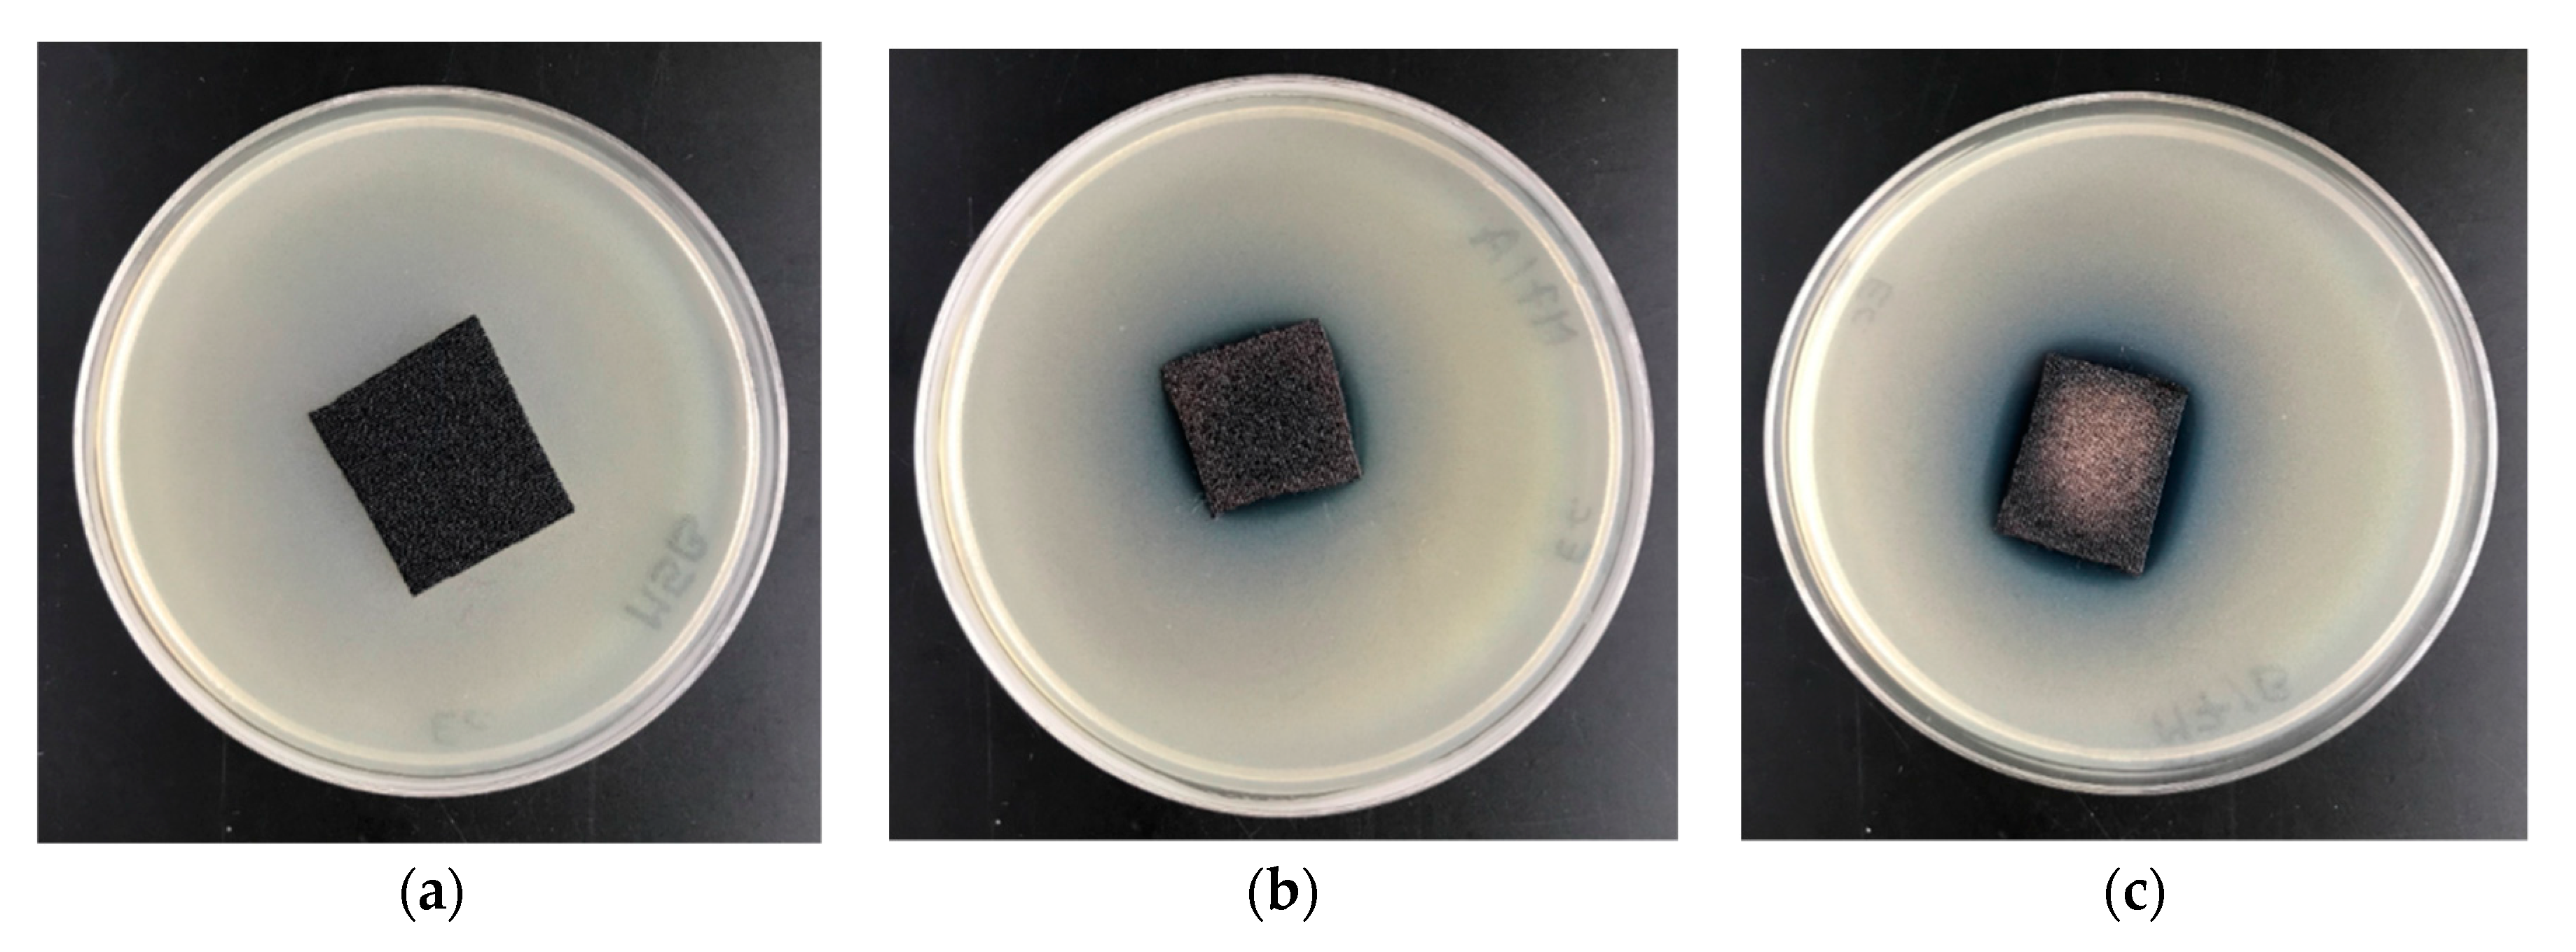
Applsci 10 06990 g008
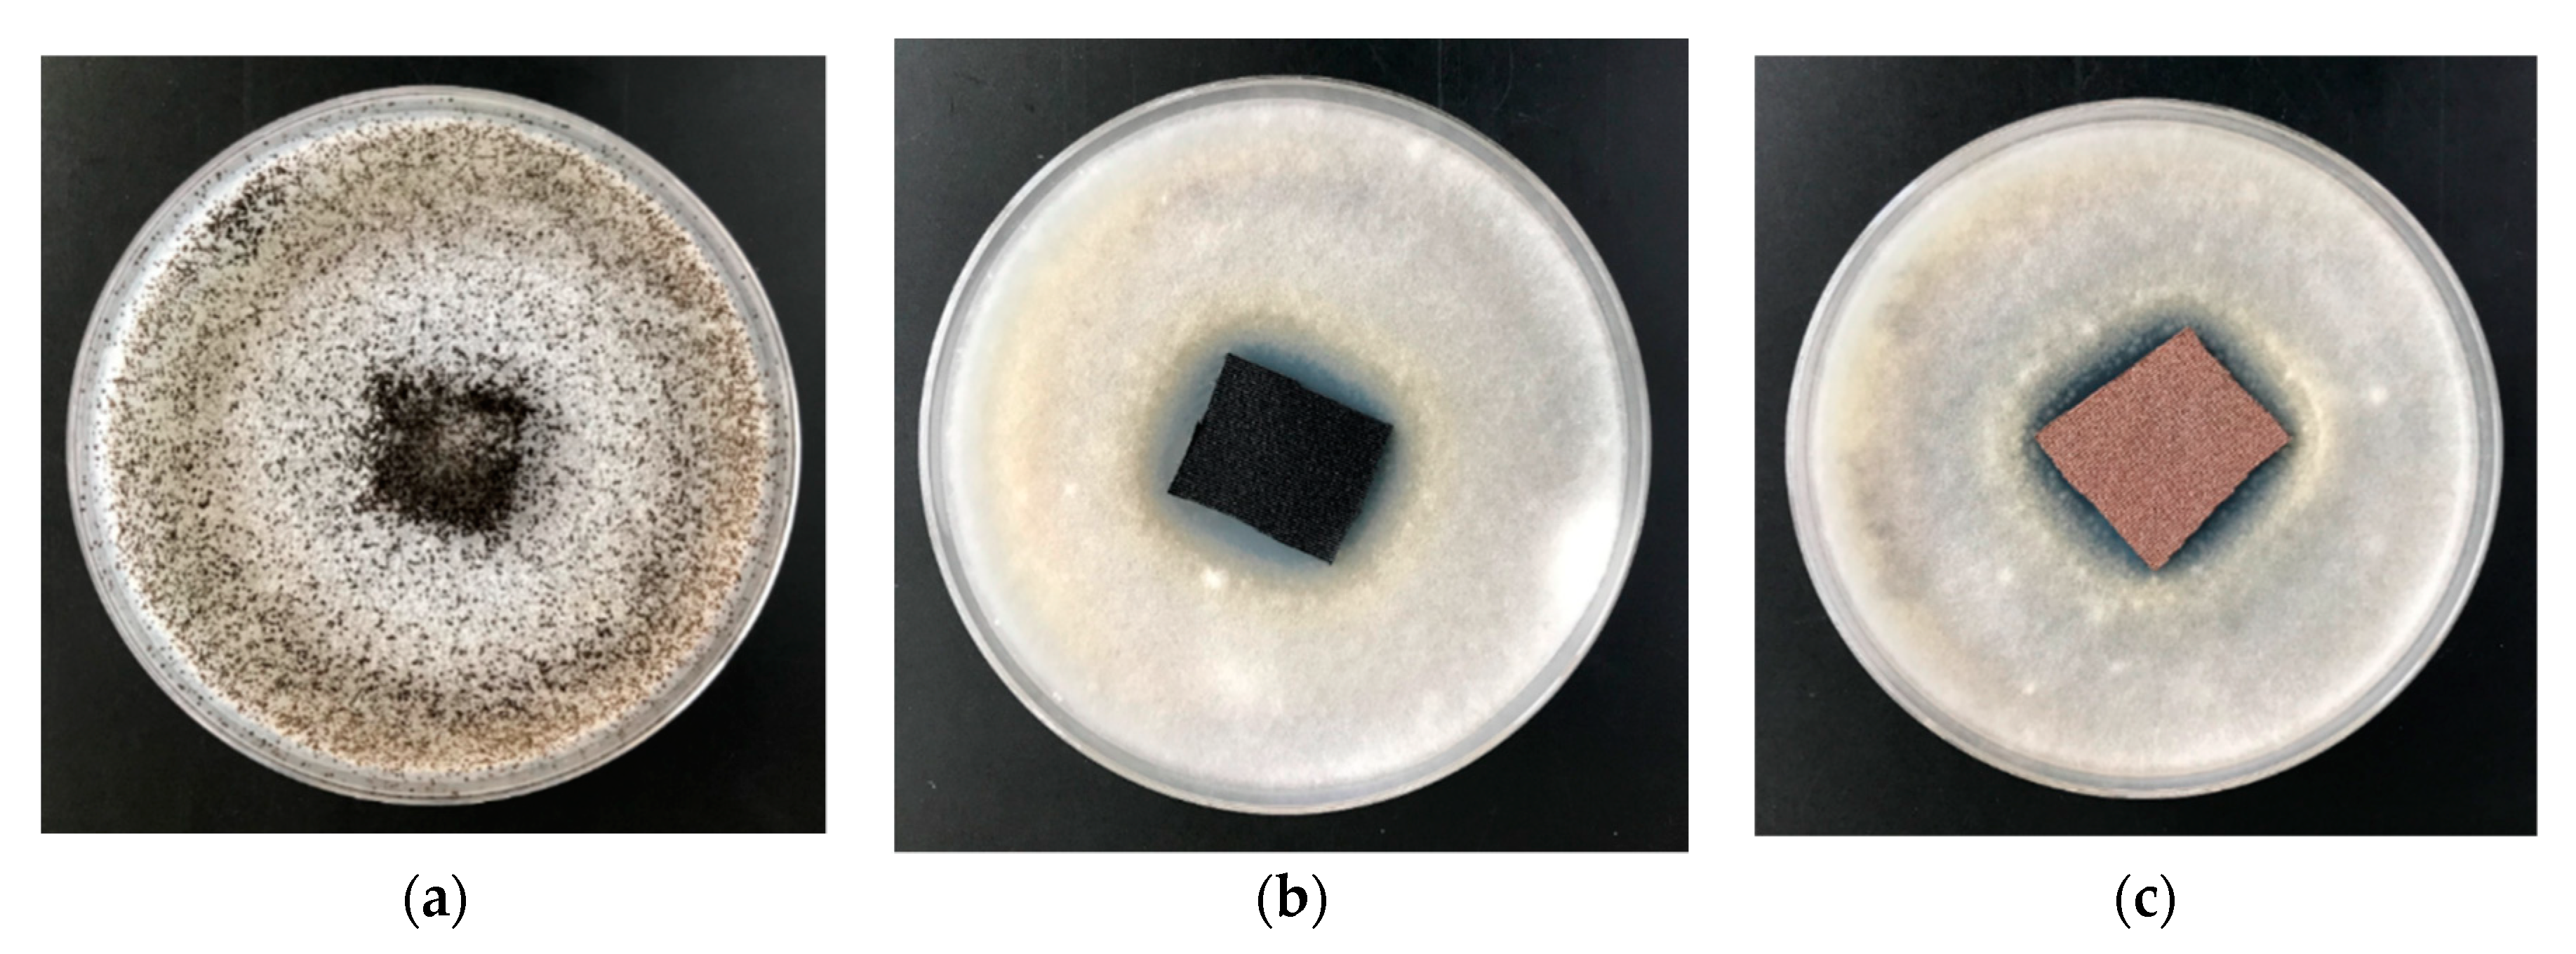
Applsci 10 06990 g009

Deposition of Copper on Polyester Knitwear Fibers by a Magnetron Sputtering System. Physical Properties and Evaluation of Antimicrobial Response of New Multi-Functional Composite Materials
Abstract
1. Introduction
2. Materials and Methods
2.1. Materials
- Knitted textile, qualitative composition: polyester—polyethylene terephthalate (95%w/w), elastane—polyether-polyurea copolymer (5%w/w), weave: interlock right, basic weight (GSM): 230 g/m2; assigned as PETE (polyethylene terephthalate-elastane, for structures see Figure 1) (IW, Lodz, Poland). The size of the textile sample was 300 mm × 150 mm.
- The copper target (Testbourne Ltd., Basingstoke, UK) with 99.99% purity. The size of the target was equal to 798 × 122 × 6 mm.
- Bacterial and Fungal Strains were purchased from Microbiologics (St. Cloud, MN, USA): Escherchia coli (ATCC 25922), Staphylococcus aureus (ATCC 6538) and fungal strains: Chaetomium globosum (ATCC 6205).
2.2. Methods
2.2.1. Magnetron Sputtering
2.2.2. SEM/EDS—Scanning Electron Microscopy/Energy-Dispersive X-ray Spectroscopy
2.2.3. FAAS—Flame Atomic Absorption Spectrometry
- Ci—metal concentration in the tested solution [mg/L];
- mi—mass of the mineralized sample [g];
- V—volume of the sample solution [mL].
2.2.4. UV-VIS Analysis and Determination of the Protective Properties Against UV Radiation
- E(λ)—the solar irradiance;
- ε(λ)—the erythema action spectrum (measure of the harmfulness of UV radiation for human skin);
- Δλ—the wavelength interval of the measurements;
- T(λ)—the spectral transmittance at wavelength λ.
2.2.5. Filtration Parameters
2.2.6. Tensile Testing
2.2.7. Thickness
2.2.8. Thermal Resistance, Steam Resistance and Steam Permeability
2.2.9. Bacterial Activity
2.2.10. Antifungal Activity
3. Results and Discussion
3.1. SEM—Scanning Electron Microscopy
3.2. Copper Determination in PETE-Cu(0)/Composites
3.3. Copper Determination by Energy-Dispersive X-ray Spectroscopy EDS
3.4. Copper Determination by Flame Atomic Absorption Spectrometry—FAAS
3.5. UV-VIS Analysis and Determination of the Protective Properties Against UV Radiation
3.6. Technical Parameters
3.6.1. Filtration Parameters
3.6.2. Tensile Strength
3.6.3. Thickness
3.6.4. Thermal Resistance
3.7. Antimicrobial Properties
3.7.1. Antibacterial Activity
3.7.2. Antifungal Activity
4. Conclusions
Author Contributions
Funding
Acknowledgments
Conflicts of Interest
References
- Klare, H.; Reinisch, G. The structure and the properties of polyalkylene terephthalates (PATP). A review. Polym. Sci. USSR 1979, 21, 2727–2745. [Google Scholar] [CrossRef]
- Pergal, M.V.; Balaban, M. Poly(Ethylene Terephthalate): Synthesis and physicochemical properties In Polyethylene Terephthalate: Uses, Properties and Degradation; Barber, N.A., Ed.; Nova Science Publishers, Inc.: Hauppauge, NY, USA, 2017; Chapter 1; pp. 1–102. [Google Scholar]
- Fahim, A.M.; Farag, A.M.; Nawwar, G.A.M.; Yakout, E.S.M.A.; Ragab, E.A. Chemistry of tere-phthalate derivatives: A review. Int. J. Environ. Waste Manag. 2019, 24, 273–301. [Google Scholar] [CrossRef]
- Beeva, D.A.; Borisov, V.A.; Mikitaev, A.K.; Ligidov, M.K.; Beev, A.A.; Barokova, E.B. Controlling the barrier properties of polyethylene terephthalate. A review. Int. Polym. Sci. Technol. 2015, 42, 45–52. [Google Scholar] [CrossRef]
- Glenz, W. Polyethylene terephthalate (PET). Kunststoffe Int. 2007, 97, 50–54. [Google Scholar]
- Matsuo, T. Fibre materials for advanced technical textiles. Text. Prog. 2008, 40, 87–121. [Google Scholar] [CrossRef]
- Gong, X.; Chen, X.; Zhou, Y. Advanced weaving technologies for high-performance fabrics. In High-Performance Apparel: Materials, Development, and Applications; McLoughlin, J., Sabir, T., Eds.; Elsevier Ltd. (Woodhead Publishing 2018): Amsterdam, The Netherlands, 2017; Chapter 3; pp. 75–112. [Google Scholar]
- Ma, Z.; Kotaki, M.; Yong, T.; He, W.; Ramakrishna, S. Surface engineering of electrospun polyethylene terephthalate (PET) nanofibers towards development of a new material for blood vessel engineering. Biomaterials 2005, 26, 2527–2536. [Google Scholar] [CrossRef]
- Kenawy, E.R.; Worley, S.D.; Broughton, R. The chemistry and applications of antimicrobial polymers: A state-of-the-art review. Biomacromolecules 2007, 8, 1359–1384. [Google Scholar] [CrossRef]
- Hadjizadeh, A.; Ajji, A.; Bureau, M.N. Preparation and characterization of NaOH treated micro-fibrous polyethylene terephthalate nonwovens for biomedical application. J. Mech. Behav. Biomed. Mater. 2010, 3, 574–583. [Google Scholar] [CrossRef]
- Peck, M.; Gebhart, D.; Dusserre, N.; McAllister, T.N.; L’Heureux, N. The evolution of vascular tissue engineering and current state of the art. Cells Tissues Organs 2011, 195, 144–158. [Google Scholar] [CrossRef]
- Jafari, S.; Hosseini Salekdeh, S.S.; Solouk, A.; Yousefzadeh, M. Electrospun polyethylene terephthalate (PET) nanofibrous conduit for biomedical application. Polym. Adv. Technol. 2020, 31, 284–296. [Google Scholar] [CrossRef]
- Vishnu, A.; Mohana, V.; Manasi, S.; Ponmalar, V. Use of polyethylene terephthalate in concrete—A brief review. Int. J. Civ. Eng. Technol. 2017, 8, 1171–1176. [Google Scholar]
- Chang, T.H.; Jung, Y.H.; Liu, D.; Mi, H.; Lee, J.; Gong, J.; Ma, Z. The applications of polyethylene terephthalate for RF flexible electronics. In Polyethylene Terephthalate: Uses, Properties and Degradation; Barber, N.A., Ed.; Nova Science Publishers, Inc.: Hauppauge, NY, USA, 2017; Chapter 2; pp. 103–153. [Google Scholar]
- Tan, H.; Li, J.; Fu, Q. Preparation and characterization of non-fouling polymer brushes on poly(Ethylene terephthalate) film surfaces. In Polymer Brushes: Substrates, Technologies, and Properties; Mittal, V., Ed.; Taylor & Francis Group, LLC, CRC: Boca Raton, FL, USA, 2012; Chapter 5; pp. 91–114. ISBN 9780429107078. [Google Scholar] [CrossRef]
- Wu, S.; Zhang, B.; Liu, Y.; Suo, X.; Li, H. Influence of surface topography on bacterial adhesion: A review (Review). Biointerphases 2018, 13, 060801. [Google Scholar] [CrossRef] [PubMed]
- Adlhart, C.; Verran, J.; Azevedo, N.F.; Olmez, H.; Keinanen-Toivola, N.M.; Gouveia, I.; Melo, L.F.; Crijns, F. Surface modifications for antimicrobial effects in the healthcare setting: A critical overview. J. Hosp. Infect. 2018, 99, 239–249. [Google Scholar] [CrossRef] [PubMed]
- Caykara, T.; Sande, M.G.; Azoia, N.; Rodrigues, L.R.; Silva, C.J. Exploring the potential of polyethylene terephthalate in the design of antibacterial surfaces. Med. Microbiol. Immunol. 2020, 209, 363–372. [Google Scholar] [CrossRef] [PubMed]
- Swar, S.; Zajícova, V.; Rysova, M.; Lovetinska-Slamborová, I.; Volesky, L.; Stibor, I. Biocompatible surface modification of poly(ethylene terephthalate) focused on pathogenic bacteria:promising prospects in biomedical applications. J. Appl. Polym. Sci. 2017, 134, 1–11. [Google Scholar] [CrossRef]
- Zhang, Z.; Zhao, Z.; Zheng, Z.; Liu, S.; Mao, S.; Li, X.; Chen, Y.; Mao, Q.; Wang, L.; Wang, F.; et al. Functionalization of polyethylene terephthalate fabrics using nitrogen plasma and silk fibroin/chitosan microspheres. Appl. Surf. Sci. 2019, 495, 143481. [Google Scholar] [CrossRef]
- Huh, M.W.; Kang, I.-K.; Lee, D.H.; Kim, W.S.; Lee, D.H.; Park, L.S.; Min, K.E.; Seo, K.H. Surface characterization and antibacterial activity of chitosan-grafted poly(ethylene terephthalate) prepared by plasma glow discharge. J. Appl. Polym. Sci. 2001, 81, 2769–2778. [Google Scholar] [CrossRef]
- Hu, S.G.; Jou, C.H.; Yang, M.C. Surface grafting of polyester fiber with chitosan and the antibacterial activity of pathogenic bacteria. J. Appl. Polym. Sci. 2002, 86, 2977–2983. [Google Scholar] [CrossRef]
- Bedel, S.; Lepoittevin, B.; Costa, L.; Leroy, O.; Dragoe, D.; Bruzaud, J.; Herry, J.M.; Guilbaud, M.; Bellon-Fontaine, M.N.; Roger, P. Antibacterial poly(ethylene terephthalate) surfaces obtained from thymyl methacrylate polymerization. J. Polym. Sci. Part A Polym. Chem. 2015, 53, 1975–1985. [Google Scholar] [CrossRef]
- Xv, J.; Li, H.; Zhang, W.; Lai, G.; Xue, H.; Zhao, J.; Tu, M.; Zeng, R. Anti-biofouling and functionalizable bioinspired chitosan-based hydrogel coating via surface photo-immobilization. J. Biomater. Sci. Polym. Ed. 2019, 30, 398–414. [Google Scholar] [CrossRef]
- Gao, F.; Jiang, M.; Liang, W.; Fang, X.; Bai, F.; Zhou, Y.; Lang, M. Co-electrospun cellulose diacetate-graft-poly(ethylene terephthalate) and collagen composite nanofibrous mats for cells culture. J. Appl. Polym. Sci. 2020, 137, 49350. [Google Scholar] [CrossRef]
- Gun Gok, Z.; Inal, M.; Bozkaya, O.; Yigitoglu, M.; Vargel, I. Production of 2-hydroxyethyl methacrylate-g-poly(ethylene terephthalate) nanofibers by electrospinning and evaluation of the properties of the obtained nanofibers. J. Appl. Polym. Sci. 2020, 137, 9257. [Google Scholar] [CrossRef]
- Olson, R.A.; Korpusik, A.B.; Sumerlin, B.S. Enlightening advances in polymer bioconjugate chemistry: Light-based techniques for grafting to and from biomacromolecules. Chem. Sci. 2020, 11, 5142–5156. [Google Scholar] [CrossRef]
- Zhang, S.; Ding, F.; Wang, Y.; Ren, X.; Huang, T.S. Antibacterial and Hydrophilic Modification of PET Fabrics by Electron Beam Irradiation Process. Fibers Polym. 2020, 21, 1023–1031. [Google Scholar] [CrossRef]
- Coen, M.C.; Lehmann, R.; Groening, P.; Schlapbach, L. Modification of the micro- and nanotopography of several polymers by plasma treatments. Appl. Surf. Sci. 2003, 207, S0169–S4332. [Google Scholar]
- Inagaki, N.; Narushim, K.; Tuchida, N.; Miyazaki, K. Surface characterization of plasma-modified poly(ethylene terephthalate) film surfaces. J. Polym. Sci. Part B Polym. Phys. 2004, 42, 3727–3740. [Google Scholar] [CrossRef]
- Chung, K.K.; Schumacher, J.F.; Sampson, E.M.; Burne, R.A.; Antonelli, P.J.; Brennan, A.B. Impact of engineered surface microtopography on biofilm formation of Staphylococcus aureus. Biointerphases 2007, 2, 89–94. [Google Scholar] [CrossRef]
- Yang, L.; Chen, J.; Guo, Y.; Zhang, Z. Surface modification of a biomedical polyethylene terephthalate (PET) by air plasma. Appl. Surf. Sci. 2009, 255, 4446–4451. [Google Scholar] [CrossRef]
- Khoffi, F.; Khalsi, Y.; Chevrier, J.; Kerdjoud, J.H.; Tazibt, A.; Heim, F. Surface modification of polymer textile biomaterials by N2 supercritical jet: Preliminary mechanical and biological performance assessment. J. Mech. Behav. Biomed. Mater. 2020, 107, 103772. [Google Scholar] [CrossRef]
- Del Hoyo-Gallego, S.; Pérez-Álvarez, L.; Gómez-Galván, F.; Lizundia, E.; Kuritka, I.; Sedlarik, V.; Laza, J.M.; Vila-Vilela, J.L. Construction of antibacterial poly(ethylene terephthalate) films via layer by layer assembly of chitosan and hyaluronic acid. Carbohydr. Polymers 2016, 143, 35–43. [Google Scholar] [CrossRef]
- Gun Gok, Z.; Gunay, K.; Arslan, M.; Yigitoglu, M.; Vargel, I. Coating of modified poly(ethylene terephthalate) fibers with sericin-capped silver nanoparticles for antimicrobial application. Polym. Bull. 2020, 77, 1649–1665. [Google Scholar] [CrossRef]
- Junthip, J.; Tabary, N.; Maton, M.; Ouerghemmi, S.; Staelens, J.N.; Cazaux, F.; Neut, C.; Blanchemain, N.; Martel, B. Release-killing properties of a textile modified by a layer-by-layer coating based on two oppositely charged cyclodextrin polyelectrolytes. Int. J. Pharm. 2020, 587, 119730. [Google Scholar] [CrossRef] [PubMed]
- Naeem, M.; Felipe, M.B.M.C.; de Medeiros, S.R.B.; Costa, T.H.C.; Libório, M.S.; Alves, C., Jr.; Nascimento, R.M.; Nascimento, I.O.; Sousa, R.R.M.; Feitor, M.C. Novel antibacterial silver coating on PET fabric assisted with hollow-cathode glow discharge. Polym. Adv. Technol. 2020, 31, 2896–2905. [Google Scholar] [CrossRef]
- Rodríguez-Alba, E.; Dionisio, N.; Pérez-Calixto, M.; Huerta, L.; García-Uriostegui, L.; Hautefeuille, M.; Vázquez-Victorio, G.; Burillo, G. Surface modification of polyethylenterephthalate film with primary amines using gamma radiation and aminolysis reaction for cell adhesion studies. Radiat. Phys. Chem. 2020, 176, 109070. [Google Scholar] [CrossRef]
- Sreeja, S.; Muraleedharan, C.V.; Varma, P.R.H.; Sailaja, G.S. Surface-transformed osteoinductive polyethylene terephthalate scaffold as a dual system for bone tissue regeneration with localized antibiotic delivery. Mater. Sci. Eng. C 2020, 109, 110491. [Google Scholar] [CrossRef] [PubMed]
- Samipour, S.; Taghvaei, H.; Mohebbi-Kalhori, D.; Rahimpour, M.R. Plasma treatment and chitosan coating: A combination for improving PET surface properties. Surf. Innov. 2020, 8, 76–88. [Google Scholar] [CrossRef]
- Jung, K.H.; Huh, M.W.; Meng, W.; Yuan, J.; Hyun, S.H.; Bae, J.S.; Hudson, S.M.; Kang, I.-K. Preparation and antibacterial activity of PET/chitosan nanofibrous mats using an electrospinning technique. J. Appl. Polym. Sci. 2007, 105, 2816–2823. [Google Scholar] [CrossRef]
- Masoomi, M.; Tavangar, M.; Razavi, S.M.R. Preparation and investigation of mechanical and antibacterial properties of poly(ethylene terephthalate)/chitosan blend. RSC Adv. 2015, 5, 79200–79206. [Google Scholar] [CrossRef]
- Jou, C.H.; Yuan, L.; Lin, S.-M.; Hwang, M.C.; Chou, W.L.; Yu, D.-G.; Yang, M.-C. Biocompatibility and antibacterial activity of chitosan and hyaluronic acid immobilized polyester fibers. J. Appl. Polym. Sci. 2007, 104, 220–225. [Google Scholar] [CrossRef]
- Pérez-Álvarez, L.; Ruiz-Rubio, L.; Azua, I.; Benito, V.; Bilbao, A.; Vilas-Vilela, J.L. Development of multiactive antibacterial multilayers of hyaluronic acid and chitosan onto poly(ethylene terephthalate). Eur. Polym. J. 2019, 112, 31–37. [Google Scholar] [CrossRef]
- Gahtan, V.; Esses, G.E.; Bandyk, D.F.; Nelson, R.T.; Dupont, E.; Mills, J.L. Antistaphylococcal activity of rifampin-bonded gelatin-impregnated dacron grafts. J. Surgical. Res. 1995, 58, 105–110. [Google Scholar] [CrossRef] [PubMed]
- Bucheńska, J.; Slomkowski, S.; Tazbir, J.; Sobolewska, E. Antibacterial poly(ethylene terephthalate) yarn containing cephalosporin type antibiotic. Fibres Text. East. Eur. 2003, 11, 41–47. [Google Scholar]
- Ginalska, G.; Osinska, M.; Uryniak, A.; Urbanik-Sypniewska, T.; Belcarz, A.; Rzeski, W.; Wolski, A. Antibacterial activity of gentamicin-bonded gelatin-sealed polyethylene terephthalate vascular prostheses. Eur. J. Vasc. Endovasc. Surg. 2005, 29, 419–424. [Google Scholar] [CrossRef]
- Shimanovich, U.; Cavaco-Paulo, A.; Nitzan, Y.; Gedanken, A. Sonochemical coating of cotton and polyester fabrics with “antibacterial” BSA and casein spheres. Chem. Eur. J. 2012, 18, 365–369. [Google Scholar] [CrossRef] [PubMed]
- Aubert-Viard, F.; Mogrovejo-Valdivia, A.; Tabary, N.; Maton, M.; Chai, F.; Neut, C.; Martel, B.; Blanchemain, N. Evaluation of antibacterial textile covered by layer-by-layer coating and loaded with chlorhexidine for wound dressing application. Mater. Sci. Eng. C 2019, 100, 554–563. [Google Scholar] [CrossRef]
- Salmoukas, C.; Ruemke, S.; Rubalskii, E.; Burgwitz, K.; Haverich, A.; Kuehn, C. Vascular graft pre-treatment with daptomycin prior to implantation prevents graft infection with Staphylococcus aureus in an in vivo model. Surg. Infect. 2020, 21, 161–168. [Google Scholar] [CrossRef] [PubMed]
- Levy, S.B.; Marshall, B. Antibacterial resistance worldwide: Causes, challenges and responses. Nat. Med. 2004, 10, 122–129. [Google Scholar] [CrossRef]
- Medici, S.; Peana, M.; Nurchi, V.M.; Lachowicz, J.I.; Crisponi, G.; Zoroddu, M.A. Noble metals in medicine: Latest advances. Coord. Chem. Rev. 2015, 284, 329–350. [Google Scholar] [CrossRef]
- Paladini, F.; Pollini, M.; Sannino, A.; Ambrosio, L. Metal-based antibacterial substrates for biomedical applications. Biomacromolecules 2015, 16, 1873–1885. [Google Scholar] [CrossRef]
- Giannousi, K.; Pantazaki, A.; Dendrinou-Samara, C. bnjmpper-Based Nanoparticles as Antimicrobials. In Nanostructures for Antimicrobial Therapy: Nanostructures in Therapeutic; Ficai, A., Grumezescu, A.M., Eds.; Elsevier Inc.: Amsterdam, The Netherlands, 2017; Chapter 23; pp. 515–529. ISBN 9780323461511. [Google Scholar]
- Chuang, K.T.; Abdullah, H.; Leu, S.J.; Cheng, K.; Bin Kuo, D.H.; Chen, H.C.; Chien, J.H.; Hu, W.T. Metal oxide composite thin films made by magnetron sputtering for bactericidal application. J. Photochem. Photobiol. A Chem. 2017, 337, 151–164. [Google Scholar] [CrossRef]
- Hoseinzadeh, E.; Makhdoumi, P.; Taha, P.; Hossini, H.; Stelling, J.; Kamal, M.A.; Ashraf, G. A review on nano-antimicrobials: Metal nanoparticles, methods and mechanisms. Curr. Drug Metab. 2017, 18, 120–128. [Google Scholar] [CrossRef] [PubMed]
- Slavin, Y.N.; Asnis, J.; Häfeli, U.O.; Bach, H. Metal nanoparticles: Understanding the mechanisms behind antibacterial activity. J. Nanobiotechnol. 2017, 15, 65. [Google Scholar] [CrossRef] [PubMed]
- Klebowski, B.; Depciuch, J.; Parlinska-Wojtan, M.; Baran, J. Applications of noble metal-based nanoparticles in medicine. Int. J. Mol. Sci. 2018, 19, 4031. [Google Scholar] [CrossRef] [PubMed]
- Sánchez-López, E.; Gomes, D.; Esteruelas, G.; Bonilla, L.; Lopez-Machado, A.L.; Galindo, R.; Cano, A.; Espina, M.; Ettecheto, M.; Camins, A.; et al. Metal-based nanoparticles as antimicrobial agents: An overview. Nanomaterials 2020, 10, 292. [Google Scholar] [CrossRef]
- Tweden, K.S.; Cameron, J.D.; Razzouk, A.J.; Bianco, RW.; Holmberg, W.R.; Bricault, RJ.; Barry, J.E.; Tobin, E. Silver modification of polyethylene terephthalate textiles for antimicrobial protection. ASAIO J. 1997, 43, 475–481. [Google Scholar] [CrossRef]
- Perelshtein, I.; Applerot, G.; Perkas, N.; Guibert, G.; Mikhailov, S.; Gedanken, A. Sonochemical coating of silver nanoparticles on textile fabrics (nylon, polyester and cotton) and their antibacterial activity. Nanotechnology 2008, 19, 245705. [Google Scholar] [CrossRef]
- Radetić, M.; Ilić, V.; Vodnik, V.; Dimitricjevic, S.; Jovanovic, P.; Šaponjić, Z.; Nedeljković, J.M. Antibacterial effect of silver nanoparticles deposited on corona-treated polyester and polyamide fabrics. Polym. Adv. Technol. 2008, 19, 1816–1821. [Google Scholar] [CrossRef]
- Gorenšek, M.; Gorjanc, M.; Bukošek, V.; Kovac, J.; Jovančić, P.; Mihailović, D. Functionalization of PET fabrics by corona and nano silver. Text. Res. J. 2010, 80, 253–262. [Google Scholar] [CrossRef]
- Chen, Y.H.; Hsu, C.C.; He, J.L. Antibacterial silver coating on poly(ethylene terephthalate) fabric by using high power impulse magnetron sputtering. Surf. Coat. Technol. 2013, 232, 868–875. [Google Scholar] [CrossRef]
- Kumar, V.; Jolivalt, C.; Pulpytel, J.; Jafari, R.; Arefi-Khonsari, F. Development of silver nanoparticle loaded antibacterial polymer mesh using plasma polymerization process. J. Biomed. Mater. Res. Part A 2013, 101, 1121–1132. [Google Scholar] [CrossRef]
- Majumdar, A.; Butola, B.S.; Thakur, S. Development and performance optimization of knitted antibacterial materials using polyester-silver nanocomposite fibres. Mater. Sci. Eng. C 2015, 54, 26–31. [Google Scholar] [CrossRef] [PubMed]
- Nguyenova, H.Y.; Vokata, B.; Zaruba, K.; Siegel, J.; Kolska, Z.; Svorcik, V.; Slepicka, P.; Reznickova, A. Silver nanoparticles grafted onto PET: Effect of preparation method on antibacterial activity. React. Funct. Polym. 2019, 145, 104376. [Google Scholar] [CrossRef]
- Li, J.X.; Wang, J.; Shen, L.R.; Xu, ZJ.; Li, P.; Wan, G.J.; Huang, N. The influence of polyethylene tere-phthalate surfaces modified by silver ion implantation on bacterial adhesion behaviour. Surf. Coat. Technol. 2007, 201, 8155–8159. [Google Scholar] [CrossRef]
- Rajabi, A.; Ghazali, M.J.; Mahmoudi, E.; Baghdadi, A.H.; Mohammad, A.W.; Mustafah, N.M.; Ohnmar, H.; Naicker, A.S. Synthesis, characterization, and antibacterial activity of Ag2O-loaded polyethylene terephthalate fabric via ultrasonic method. Nanomaterials 2019, 9, 450. [Google Scholar] [CrossRef] [PubMed]
- Mihailović, D.; Šaponjić, Z.; Radoičić, M.; Radetic, T.; Jovancic, P.; Nedeljković, J.; Radetić, M. Functionalization of polyester fabrics with alginates and TiO2 nanoparticles. Carbohyd. Polym. 2010, 79, 526–532. [Google Scholar] [CrossRef]
- Mihailović, D.; Šaponjić, Z.; Molina, R.; Radoičić, M.; Esquena, J.; Jovančić, P.; Nedeljković, J.; Radetić, M. Multifunctional properties of polyester fabrics modified by corona discharge/air RF plasma and colloidal TiO2 nanoparticles. Polym. Compos. 2011, 32, 390–397. [Google Scholar] [CrossRef]
- Xu, Y.; Wen, W.; Wu, J.M. Titania nanowires functionalized polyester fabrics with enhanced photocatalytic and antibacterial performances. J. Hazard. Mater. 2018, 343, 285–297. [Google Scholar] [CrossRef]
- Touhid, S.S.B.; Shawon, M.R.K.; Khoso, N.A.; Xu, Q.; Pan, D.; Liu, X. TiO2/Cu composite NPs coated polyester fabric for the enhancement of antibacterial durability. IOP Conf. Ser. Mater. Sci. Eng. 2020, 774, 012114. [Google Scholar] [CrossRef]
- Deng, B.; Yan, X.; Wei, Q.; Gao, W. AFM characterization of nonwoven material functionalized by ZnO sputter coating. Mater. Charact. 2007, 58, 854–858. [Google Scholar] [CrossRef]
- Fiedot-Toboła, M.; Ciesielska, M.; Maliszewska, I.; Rac-Rumiejowska, O.; Suchorska-Wożniak, P.; Teterycz, H.; Bryjak, M. Deposition of zinc oxide on different polymer textiles and their antibacterial properties. Materials 2018, 11, 707. [Google Scholar] [CrossRef]
- Yuan, X.; Xu, W.; Huang, F.; Chen, D.; Wei, Q. Polyester fabric coated with Ag/ZnO composite film by magnetron sputtering. Appl. Surf. Sci. 2016, 390, 863–869. [Google Scholar] [CrossRef]
- Weichold, O.; Goel, P.; Lehmann, K.H.; Möller, M. Solvent-crazed PET fibers imparting antibacterial activity by release of Zn2+. J. Appl. Polym. Sci. 2009, 112, 2634–2640. [Google Scholar] [CrossRef]
- Yang, X.; Yang, J.; Wang, L.; Ran, B.; Jia, Y.; Zhang, L.; Yang, G.; Shao, H.; Jiang, X. Pharmaceutical intermediate-modified gold nanoparticles: Against multidrug-resistant bacteria and wound-healing application via an electrospun scaffold. ACS Nano 2017, 11, 5737–5745. [Google Scholar] [CrossRef] [PubMed]
- Chen, Y.H.; Wu, G.W.; He, J.L. Antimicrobial brass coatings prepared on poly(ethylene terephthalate) textile by high power impulse magnetron sputtering. Mater. Sci. Eng. C 2015, 48, 41–47. [Google Scholar] [CrossRef]
- Ahmad, S.; Ashraf, M.; Ali, A.; Shaker, K.; Umair, M.; Afzal, A.; Nawab, Y.; Rasheed, A. Preparation of conductive polyethylene terephthalate yarns by deposition of silver & copper nanoparticles. Fibres Text. East. Eur. 2017, 25, 25–30. [Google Scholar] [CrossRef]
- Nguyen, V.T.; Trinh, K.S. In situ deposition of copper nanoparticles on polyethylene terephthalate filters and antibacterial testing against Escherichia coli and Salmonella enterica. Braz. J. Chem. Eng. 2019, 36, 1553–1560. [Google Scholar] [CrossRef]
- Zhou, J.; Fei, X.; Li, C.; Yu, S.; Hu, Z.; Xiang, H.; Sun, B.; Zhu, M. Integrating Nano-Cu2O@ZrP into in situ polymerized polyethylene terephthalate (PET) fibers with enhanced mechanical properties and antibacterial activities. Polymers 2019, 11, 113. [Google Scholar] [CrossRef]
- Scopus Base. 5212 Documents Results on Antibacterial& Copper. Available online: https://www-1scopus-1com-10000147v00b6.han.p.lodz.pl/results/results.uri?numberOfFields=0&src=s&clickedLink=&edit=&editSaveSearch=&origin=searchbasic&authorTab=&affiliationTab=&advancedTab=&scint=1&menu=search&tablin=&searchterm1=Antibacterial+Copper&field1=TITLE_ABS_KEY&dateType=Publication_Date_Type&yearFrom=Before+1960&yearTo=Present&loadDate=7&documenttype=All&accessTypes=All&resetFormLink=&st1=Antibacterial+Copper&st2=&sot=b&sdt=b&sl=35&s=TITLE-ABS-KEY%28Antibacterial+Copper%29&sid=7456a8ca6e782e4746a73fa9c19ff5e7&searchId=7456a8ca6e782e4746a73fa9c19ff5e7&txGid=271a497002bc4a7ce75a80cc22cd9308&sort=plf-f&originationType=b&rr= (accessed on 10 September 2020).
- Khodashenas, B.; Ghorbani, H.R. Synthesis of copper nanoparticles: An overview of the various methods. Korean J. Chem. Eng. 2014, 31, 1105–1109. [Google Scholar] [CrossRef]
- Camacho-Flores, B.A.; Martínez-Álvarez, O.; Arenas-Arrocena, M.C.; Garcia-Contreras, R.; Argueta-Figueroa, L.; de la Fuente-Hernández, J.; Acosta-Torres, L.S. Copper: Synthesis techniques in nanoscale and powerful application as an antimicrobial agent. J. Nanomater. 2015, 415238. [Google Scholar] [CrossRef]
- Rafique, M.; Shaikh, A.J.; Rasheed, R.; Tahir, M.B.; Bakhat, H.F.; Rafique, M.S.; Rabbani, F. A review on synthesis, characterization and applications of copper nanoparticles using green method. Nanomaterials 2017, 12, 1750043. [Google Scholar] [CrossRef]
- Grass, G.; Rensing, C.; Solioz, M. Metallic copper as an antimicrobial surface. Appl. Environ. Microbiol. 2011, 77, 1541–1547. [Google Scholar] [CrossRef] [PubMed]
- Radetzki, M. Seven thousand years in the service of humanity—The history of copper, the red metal. Resour. Policy 2009, 34, 176–184. [Google Scholar] [CrossRef]
- Barceloux, D.G. Copper. Clin. Toxicol. 1999, 37, 217–230. [Google Scholar] [CrossRef] [PubMed]
- Hans, M.; Erbe, A.; Mathews, S.; Chen, Y.; Solioz, M.; Mücklich, F. Role of copper oxides in contact killing of bacteria. Langmuir 2013, 29, 16160–16166. [Google Scholar] [CrossRef]
- Hans, M.; Mathews, S.; Mucklich, F.; Solioz, M. Physicochemical properties of copper important for its antibacterial activity and development of a unified model. Biointerphases 2016, 11, 018902. [Google Scholar] [CrossRef]
- Ingle, A.P.; Duran, N.; Rai, M. Bioactivity, mechanism of action, and cytotoxicity of copper-based nanoparticles: A review. Appl. Microbiol. Biotechnol. 2014, 98, 1001–1009. [Google Scholar] [CrossRef]
- Dalecki, A.G.; Crawford, C.L.; Wolschendorf, F. Copper and antibiotics: Discovery, modes of action, and opportunities for medicinal applications. Adv. Microb. Physiol. 2017, 70, 193–260. [Google Scholar] [CrossRef]
- Vincent, M.; Duval, R.E.; Hartemann, P.; Engels-Deutsch, M. Contact killing and antimicrobial properties of copper. J. Appl. Microbiol. 2018, 124, 1032–1046. [Google Scholar] [CrossRef]
- Fowler, L.; Engqvist, H.; Öhman-Mägi, C. Effect of copper ion concentration on bacteria and cells. Materials 2019, 12, 3798. [Google Scholar] [CrossRef]
- Bastos, C.A.P.; Faria, N.; Wills, J.; Malmberg, P.; Scheers, N.; Rees, P.; Powell, J.J. Copper nanoparticles have negligible direct antibacterial impact. NanoImpact 2020, 17, 100192. [Google Scholar] [CrossRef]
- Kobayashi, Y.; Yasuda, Y.; Morita, T. Recent advances in the synthesis of copper-based nanoparticles for metal-metal bonding processes. J. Sci. Adv. Mater. Devices 2016, 1, 413–430. [Google Scholar] [CrossRef][Green Version]
- Fernández-Arias, M.; Boutinguiza, M.; del Val, J.; Riveiro, A.; Rodriguez, D.; Arias-Gonzalez, F.; Gil, J.; Pou, J. Fabrication and deposition of copper and copper oxide nanoparticles by laser ablation in open air. Nanomaterials 2020, 10, 300. [Google Scholar] [CrossRef] [PubMed]
- Wei, Q.; Xiao, X.; Hou, D.; Ye, H.; Huang, F. Characterization of nonwoven material functionalized by sputter coating of copper. Surf. Coat. Technol. 2008, 202, 2535–2539. [Google Scholar] [CrossRef]
- Segura, G.; Guzmán, P.; Zuñiga, P.; Chaves, S.; Barrantes, Y.; Navarro, G.; Asenjo, J.; Guadamuz, S.; Vargas, V.I.; Chaves, J. Copper deposition on fabrics by rf plasma sputtering for medical applications. J. Phys. Conf. Ser. 2015, 591, 012046. [Google Scholar] [CrossRef]
- Tan, X.Q.; Liu, J.Y.; Niu, J.R.; Liu, J.Y.; Tian, J.Y. Recent progress in magnetron sputtering technology used on fabrics. Materials 2018, 11, 1953. [Google Scholar] [CrossRef]
- Kudzin, Z.H.; Kudzin, M.H.; Drabowicz, J.; Stevens, C.V. Aminophosphonic acids-phosphorus analogues of natural amino acids. Part 1: Syntheses of α-aminophosphonic acids. Curr. Org. Chem. 2011, 15, 2015–2071. [Google Scholar] [CrossRef]
- Kudzin, Z.H.; Depczyński, R.; Kudzin, M.H.; Łuczak, J.; Drabowicz, J. 1-(N-Trifluoroacetylamino)alkylphosphonic acids: Synthesis and properties. Amino Acids 2007, 33, 663–667. [Google Scholar] [CrossRef]
- Kudzin, M.H.; Mrozińska, Z.; Walawska, A.; Sójka-Ledakowicz, J. Biofunctionalization of textile materials. 1. Biofunctionalization of poly(propylene) (PP) nonwovens fabrics by Alafosfalin. Coatings 2019, 9, 412. [Google Scholar] [CrossRef]
- Kudzin, M.H.; Mrozińska, Z. Biofunctionalization of textile materials. 2. Antimicrobial modification of poly(lactide) (PLA) nonwoven fabrics by fosfomycin. Polymers 2020, 12, 768. [Google Scholar] [CrossRef]
- Kudzin, M.H.; Mrozińska, Z. Biofunctionalization of textile materials. 3. Biofunctionalization of poly(lactide) (PLA) nonwovens fabrics by KI. Coatings 2020, 10, 593. [Google Scholar] [CrossRef]
- Shahidi, S.; Ghoranneviss, M.; Moazzenchi, B.; Rashidi, A.; Mirjalili, M. Investigation of antibacterial activity on cotton fabrics with cold plasma in the presence of a magnetic field. Plasma Process. Polymers 2007, 4, 1098–1103. [Google Scholar]
- Badaraev, A.D.; Nemoykina, A.L.; Bolbasov, E.N.; Tverdokhlebov, S.I. PLLA scaffold modification using magnetron sputtering of the copper target to provide antibacterial properties. Res. Technol. 2017, 3, 204–211. [Google Scholar] [CrossRef]
- Gorberg, B.L.; Ivanov, A.A.; Mamontov, O.V.; Stegnin, V.A.; Titov, V.A. Modification of textile materials by the deposition of nanocoatings by magnetron ion-plasma sputtering. Russ. J. Gen. Chem. 2013, 83, 157–163. [Google Scholar] [CrossRef]
- Locatelli, P.; Woutters, S.; Lindsay, C.; Schreder, S.L.M.; Hobdell, J.H.; Saian, A. Synthesis of polyurea–polyether nanoparticles via spontaneous nanoprecipitation. RSC Adv. 2015, 5, 41668. [Google Scholar] [CrossRef]
- Kudzin, M.H.; Mrozińska, Z.; Kaczmarek, A.; Lisiak-Kucińska, A. Deposition of Copper on Poly(Lactide) Non-Woven Fabrics by Magnetron Sputtering–Fabrication of New Multi-Functional, Antimicrobial Composite. Materials 2020, 13, 3971. [Google Scholar] [CrossRef]
- ISO 15632:2012. Microbeam Analysis–Selected Instrumental Performance Parameters for the Specification and Checking of Energy-Dispersive X-ray Spectrometers for Use in Electron Probe Microanalysis; International Organization for Standardization: Geneva, Switzerland, 2012. [Google Scholar]
- Analytical Methods for Atomic Absorption Spectroscopy; The Perkin-Elmer Corporation, 1996; Volume 46, Available online: www.perkinelmer.com (accessed on 3 July 2020).
- EN 137581:2002. Textiles. Solar UV Protective Properties. Method of Test for Apparel Fabrics; International Organization for Standardization: Geneva, Switzerland, 2002. [Google Scholar]
- EN ISO 9237:1998. Textiles. Determination of the Permeability of Fabrics to Air; International Organization for Standardization: Geneva, Switzerland, 1998. [Google Scholar]
- EN ISO 10319:2015. Geosynthetics–Wide-Width Tensile Test; International Organization for Standardization: Geneva, Switzerland, 2015. [Google Scholar]
- EN ISO 5084:1999. Textiles–Determination of Thickness of Textiles and Textile Products; International Organization for Standardization: Geneva, Switzerland, 1999. [Google Scholar]
- EN ISO 11092:20141–1. Textiles–Physiological Effects–Measurement of Thermal and Water-Vapour Resistance Under Steady-State Conditions; International Organization for Standardization: Geneva, Switzerland, 2014. [Google Scholar]
- EN ISO 20645:2006. Textile Fabrics. Determination of Antibacterial Activity—Agar Diffusion Plate Test; International Organization for Standardization: Geneva, Switzerland, 2006. [Google Scholar]
- PN EN 14119: 2005 Testing of Textiles. Evaluation of the Action of Microfungi. Visual Method; International Organization for Standardization: Geneva, Switzerland, 2005. [Google Scholar]
- Gong, H.; Ozgen, B. Engineering of High-Performance Textiles. 5–Fabric structures: Woven, knitted, or nonwoven. Text. Inst. Book Ser. 2018, 107–131. [Google Scholar] [CrossRef]
- Legois, Y.; Aucouturier, M.; Ollivier, E.; Darque-Ceretti, E.; Macheto, P. Adhesion mechanism of copper films deposited by magnetron sputtering on polyamide composites. Surf. Eng. 1998, 14, 259–264. [Google Scholar] [CrossRef]
- Ringenbach, A.; Jugnet, Y.; Duc, T.M. Interfacial Chemistry in Al and Cu metallization of untreated and plasma treated polyethylene and polyethyleneterephthalate. J. Adhes. Sci. Technol. 1995, 9, 1209–1228. [Google Scholar] [CrossRef]
- Gollier, P.A.; Bertrand, P. Diffusion of copper in polymer during the metallization of PET. J. Adhesion. 1996, 58, 173–182. [Google Scholar] [CrossRef]
- Bertrand, P.; Lambert, P.; Travaly, Y. Polymer metallization: Low energy ion beam surface modification to improve adhesion. Nucl. Instr. Meth. Phys. Res. B 1997, 131, S0168–S0583. [Google Scholar] [CrossRef]
- Zhu, Z.; Kelley, M.J. Poly(ethylene terephthalate) surface modification by deep UV (172 nm) irradiation. Appl. Surf. Sci. 2004, 236, 416–425. [Google Scholar] [CrossRef]
- Zhu, Z.; Kelley, M.J. Effect of deep UV (172 nm) irradiation on PET: ToF/SIMS analysis. Appl. Surf. Sci. 2004, 231, 302–308. [Google Scholar] [CrossRef]
- Teng, C.; Yu, M. Preparation and property of poly(ethylene terephthalate) fibers providing ultraviolet radiation protection. J. Appl. Polym. Sci. 2003, 88, 1180–1185. [Google Scholar] [CrossRef]
- Dimitrovski, K.; Sluga, F.; Urbas, R. Evaluation of the structure of monofilament PET woven fabrics and their UV protection properties. Text. Res. J. 2010, 80, 1027–1037. [Google Scholar] [CrossRef]
- Urbas, R.; Sluga, F.; Miljković, J.; Bartenjev, I. Comparison of in vitro and in vivo ultraviolet protective properties of PET textile samples. Acta Dermatovener. APA 2012, 21, 11–14. [Google Scholar]
- Bunsell, A.R. Handbook of Properties of Textile and Technical Fibres; Elsevier Ltd.: Amsterdam, The Netherlands, 2018. [Google Scholar]

| PETE | PETE-Cu(0) a | |||||||
| PETE-Cu(0)-1 a | ||||||||
| PETE-Cu(0)-1.1 c | PETE-Cu(0)-1.2 c | |||||||
| Element | C | O | C | O | Cu | C | O | Cu |
| % b,c | 61.8 | 37.8 | 19.90 | 4.40 | 75.60 | 61.40 | 38.30 | - |
| Std. deviation | 0.16 | 0.16 | 0.82 | 0.06 | 0.79 | 0.14 | 0.16 | - |
| PETE | PETE-Cu(0)-2 a | |||||||
| PETE-Cu(0)-2.1 d | PETE-Cu(0)-2.2 d | |||||||
| Element | C | O | C | O | Cu | C | O | Cu |
| % b | 62.1 | 37.5 | 17.70 | 5.93 | 74.78 | 22.83 | 6.14 | 70.88 |
| Std. deviation | 0.16 | 0.16 | 1.70 | 0.45 | 0.26 | 1.47 | 0.71 | 2.20 |
| Sample Name | Copper Deposition Time [min] | Copper Concentration Determined | ||
|---|---|---|---|---|
| [g/kg] | Percentage [%: g/100 g] | Molality [m: mmol/kg] | ||
| PETE | - | 0.026 | 0.003 | 0.0004 |
| PETE-Cu(0)-1 | 10 | 6.701 | 0.670 | 0.105 |
| PETE-Cu(0)-2 | 20 | 14.036 | 1.404 | 0.221 |
| Parameter | PETE | PETE-Cu(0) | |
|---|---|---|---|
| PETE-Cu(0)-1 | PETE-Cu(0)-2 | ||
| UPF | 37 | >50 | >50 |
| Parameter | PETE | PETE-Cu(0) | ||
|---|---|---|---|---|
| PETE-Cu(0)-1 | PETE-Cu(0)-2 | |||
| Average air permeability [mm/s], pressure decrease: | 100 Pa | 65.5 ± 1.5 | 54.5 ± 1.0 | 51.8 ± 1.0 |
| 200 Pa | 147.0 ± 4.0 | 123.0 ± 2.0 | 117.0 ± 2.0 | |
| Parameter | PETE | PETE-Cu(0) | ||||
|---|---|---|---|---|---|---|
| PETE-Cu(0)-1 | PETE-Cu(0)-2 | |||||
| Longitudinal | Horizontal | Longitudinal | Horizontal | Longitudinal | Horizontal | |
| Tensile strength [kN/m] | 7.0 ± 0.26 | 6.2 ± 0.10 | 7.8 ± 0.20 | 6.0 ± 0.52 | 7.6 ± 0.14 | 6.0 ± 0.26 |
| Elongation at maximum load [%] | 375 ± 9.35 | 421 ± 13.7 | 403 ± 6.76 | 405 ± 20.1 | 396 ± 6.75 | 413 ± 24.7 |
| Parameter | PETE | PETE-Cu(0) | ||
|---|---|---|---|---|
| PETE-Cu(0)-1 | PETE-Cu(0)-2 | |||
| Average thickness [mm] | 1 kPa | 0.66 ± 0.02 | 0.67 ± 0.02 | 0.67 ± 0.02 |
| Parameter | PET | PETE-Cu(0) | |
|---|---|---|---|
| PETE-Cu(0)-1 | PETE-Cu(0)-2 | ||
| Thermal resistance [m2K/W] | 0.004 | 0.007 | 0.009 |
| Steam resistance [m2Pa/W] | 2.770 | 2.820 | 3.240 |
| Steam permeability [g/m2Pah] | 0.537 | 0.528 | 0.459 |
| Sample Name | Average Inhibition Zones for Bacterial Growth (mm) | |
|---|---|---|
| E. coli | S. aureus | |
| PETE | 0 | 0 |
| PETE-Cu(0)-1 | 1 | 1 |
| PETE-Cu(0)-2 | 2 | 1 |
| Sample Name | Fungal Average Inhibition Zone (mm) | |
|---|---|---|
| PETE | 0 | Visible growth on sample surface |
| PETE-Cu(0)-1 | 3 | No visible growth on sample surface |
| PETE-Cu(0)-2 | 3 | |
© 2020 by the authors. Licensee MDPI, Basel, Switzerland. This article is an open access article distributed under the terms and conditions of the Creative Commons Attribution (CC BY) license (http://creativecommons.org/licenses/by/4.0/).
Share and Cite
Kudzin, M.H.; Kaczmarek, A.; Mrozińska, Z.; Olczyk, J. Deposition of Copper on Polyester Knitwear Fibers by a Magnetron Sputtering System. Physical Properties and Evaluation of Antimicrobial Response of New Multi-Functional Composite Materials. Appl. Sci. 2020, 10, 6990. https://doi.org/10.3390/app10196990
Kudzin MH, Kaczmarek A, Mrozińska Z, Olczyk J. Deposition of Copper on Polyester Knitwear Fibers by a Magnetron Sputtering System. Physical Properties and Evaluation of Antimicrobial Response of New Multi-Functional Composite Materials. Applied Sciences. 2020; 10(19):6990. https://doi.org/10.3390/app10196990
Chicago/Turabian StyleKudzin, Marcin H., Anna Kaczmarek, Zdzisława Mrozińska, and Joanna Olczyk. 2020. "Deposition of Copper on Polyester Knitwear Fibers by a Magnetron Sputtering System. Physical Properties and Evaluation of Antimicrobial Response of New Multi-Functional Composite Materials" Applied Sciences 10, no. 19: 6990. https://doi.org/10.3390/app10196990
APA StyleKudzin, M. H., Kaczmarek, A., Mrozińska, Z., & Olczyk, J. (2020). Deposition of Copper on Polyester Knitwear Fibers by a Magnetron Sputtering System. Physical Properties and Evaluation of Antimicrobial Response of New Multi-Functional Composite Materials. Applied Sciences, 10(19), 6990. https://doi.org/10.3390/app10196990

